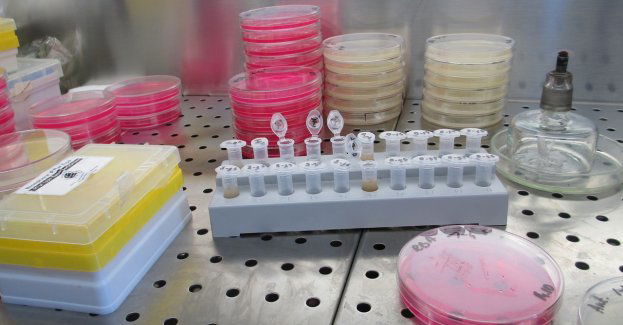

Jak żyć po czterdziestce?
fot. nadesłane
To pytanie zadaje sobie niejeden facet, przy okazji 40 tych urodzin. Po osiągnięciu tego wieku (biologicznego), w organizmie mężczyzny dochodzi do bardzo wielu zmian. Wówczas trzeba solidnie zadbać o swoje zdrowie, przeprowadzić badania i skorygować nawyki i dostosować sposób odżywiania. Czas rozpocząć drugą młodość.
REKLAMA
Zmiany zachodzą po 40 roku życia?
Zmiany po 40 roku życia są spowodowane spadkiem poziom testosteronu produkowanego w jądrach i dehydroepiandrosteronu produkowanego w nadnerczach. Wywołuje to szereg nieprzyjemnych konsekwencji, które obniżają sprawność fizyczną i psychiczną. Na pierwszy plan wychodzą problemy ze zdrowiem seksualnym i obniżonym libido. Plemniki produkowane są w niewystarczającej ilości, są niedostatecznie odżywione, co w konsekwencji może prowadzić do niepłodności. Spadek poziomu hormonów to także obniżona witalność, utrata siły mięśniowej, obniżona jędrność skóry, a nawet obniżona pewność siebie i samoocena. Aby zachodzące zmiany nie przeszkadzały w codziennym funkcjonowaniu należy zadbać o wprowadzenie zmian, które wzmocnią i uodpornią organizm.
Podatność na choroby
Wraz z wiekiem wzrasta podatność na występowanie niektórych chorób. Dodatkowo, predyspozycje genetyczne i mutacje w specyficznych genach podwyższają ryzyko zachorowalności. Po 40 roku życia szczególnie rośnie ryzyko rozwoju chorób takich jak: choroby serca, choroby płuc, udar mózgu, cukrzyca typu 2, nowotwory (zwłaszcza prostaty, płuc i jelita grubego), miażdżyca, osteoporoza; nadciśnienie, zakrzepica, choroby reumatyczne i zwyrodnieniowe.
Profil czterdziestolatka
Jeśli jeszcze nie wykonałeś odpowiednich badań, to czas najwyższy to zmienić. Nieprawidłowości w wynikach są pierwszym sygnałem rozwoju anemii, cukrzycy, miażdżycy, zaburzeń gospodarki elektrolitowej i magnezowej. Podstawowe badania określają równowagę hormonalną i diagnozują zaburzenia, które wpływają na sprawność seksualną, psychiczną i intelektualną. Wykonaj przede wszystkim podstawowe badania takie jak:
Profil czterdziestolatka
Jeśli chcesz czuć się zdrowo i jednocześnie zachować dobry wygląd, musisz pamiętać o dostarczeniu wszystkich niezbędnych składników odżywczych. Wielu mężczyzn po 40 roku życia godzi się na swój “piwny brzuszek”. Pamiętaj, że nie jest on ani zdrowy, ani atrakcyjny, dlatego spróbuj się go pozbyć zanim będzie za późno.
Oto kilka prostych zasad:
Odzyskaj męskość!
Mężczyźni po 40 roku życia bardzo często skarżą się na obniżenie libido i problemy z erekcją. Często zamiast walczyć z problemem zwyczajnie poddają się, pogrążają się w depresji i obniżonym poczuciu własnej wartości. Myślisz o niebieskich tabletkach? Pamiętaj, że “leczą” one tylko chwilowo, przykry objaw bardziej złożonej dolegliwości.
Jednak nie poddawaj się – to efekt – cena życia w rozwiniętej cywilizacji. Odpowiednie postępowanie lecznicze przywróci sprawność seksualną i pozwoli na ponowny powrót erekcji.
Aneta Strelau mgr dietetyki klinicznej, certyfikowany europejski specjalista leczenia otyłości (cert. SCOPE), Członkini Europejskiej Federacji Stowarzyszeń Dietetyków DIETS/ EFAD, Polskiego Stowarzyszenia Osób z Celiakią i Na Diecie Bezglutenowej, Polskiego Towarzystwa Dietetyki, Polskiego Towarzystwa Diabetologicznego, wiceprezes Fundacji promującej sport wśród dzieci i młodzieży „Warszawska Asocjacja Rugby. Właścicielka Poradni ,,Dietetyki Klinicznej Strelau”, Autorka ,,Poradnika dietetycznego dla Pacjenta z cukrzyca 2 cz. I” Poradnika dietetycznego dla Pacjentów z cukrzyca 2 cz. II” , ,, Dieta dla Dziecka”, ‘’Żywienie osób starszych w praktyce”.
Specjalista w zakresie leczenia otyłości oraz dietoterapii chorób autoimmunologicznych dzieci i dorosłych. Zajmuje się również poradnictwem dla dzieci objętymi opieką specjalistycznych poradni zaburzeń neurorozwojowych na terenie Warszawy. Wykładowca, uczestniczka licznych kongresów dotyczących żywienia klinicznego i chorób metabolicznych. Ekspert w licznych kampaniach edukacyjnych, w programach TV oraz w audycjach radiowych.
Zmiany po 40 roku życia są spowodowane spadkiem poziom testosteronu produkowanego w jądrach i dehydroepiandrosteronu produkowanego w nadnerczach. Wywołuje to szereg nieprzyjemnych konsekwencji, które obniżają sprawność fizyczną i psychiczną. Na pierwszy plan wychodzą problemy ze zdrowiem seksualnym i obniżonym libido. Plemniki produkowane są w niewystarczającej ilości, są niedostatecznie odżywione, co w konsekwencji może prowadzić do niepłodności. Spadek poziomu hormonów to także obniżona witalność, utrata siły mięśniowej, obniżona jędrność skóry, a nawet obniżona pewność siebie i samoocena. Aby zachodzące zmiany nie przeszkadzały w codziennym funkcjonowaniu należy zadbać o wprowadzenie zmian, które wzmocnią i uodpornią organizm.
Podatność na choroby
Wraz z wiekiem wzrasta podatność na występowanie niektórych chorób. Dodatkowo, predyspozycje genetyczne i mutacje w specyficznych genach podwyższają ryzyko zachorowalności. Po 40 roku życia szczególnie rośnie ryzyko rozwoju chorób takich jak: choroby serca, choroby płuc, udar mózgu, cukrzyca typu 2, nowotwory (zwłaszcza prostaty, płuc i jelita grubego), miażdżyca, osteoporoza; nadciśnienie, zakrzepica, choroby reumatyczne i zwyrodnieniowe.
Profil czterdziestolatka
Jeśli jeszcze nie wykonałeś odpowiednich badań, to czas najwyższy to zmienić. Nieprawidłowości w wynikach są pierwszym sygnałem rozwoju anemii, cukrzycy, miażdżycy, zaburzeń gospodarki elektrolitowej i magnezowej. Podstawowe badania określają równowagę hormonalną i diagnozują zaburzenia, które wpływają na sprawność seksualną, psychiczną i intelektualną. Wykonaj przede wszystkim podstawowe badania takie jak:
- Morfologia. To proste, tanie i bezbolesne badanie pomoże zdiagnozować zbyt wysoki poziom cholesterolu (zagrożenie miażdżycy naczyń), insulinooporność (stan przedcukrzycowy), a nawet niektóre nowotwory. Badanie powinno wykonywać się co najmniej raz do roku.
- Poziom glukozy we krwi. Pomaga określić zagrożenie związane z cukrzycą. Podatność na tę chorobę wzrasta wraz z wiekiem, dlatego niezwykle ważne jest, by stale kontrolować poziom cukru.
- Ogólne badanie moczu. Substancje w moczu to informacja na temat tego, co złego dzieje się w naszym organizmie. Odczyn zasadowy, obecność białka, występowanie bakterii, drożdzy, pasożytów mogą świadczyć o uszkodzeniu nerek lub kamicy nerkowej.
- Antygen gruczołu krokowego (PSA). Nawet jeśli nie odczuwasz dolegliwości, powinieneś wykonać to badanie. PSA to marker nowotworowy gruczołu krokowego, który pozwala wykryć go na dość wczesnym etapie. Jeśli zależy ci na dokładnej diagnozie, wybierz się do urologa, który zbada gruczoł krokowy per rectum. Można wówczas wykryć nowotwory gruczołu krokowego i jelita grubego.
- Poziom testosteronu. Określenie poziomu testosteronu może być pomocne w wyjaśnieniu przyczyn problemów związanych z erekcją i obniżonym libido. Zmniejszone stężenie hormonu może świadczyć o uszkodzeniu jąder, które jest spowodowane urazem mechanicznym, obecnością wirusa lub nadmiernym spożyciem alkoholu. Zbyt wysoki poziom hormonu to natomiast podejrzenie rozwoju guza jądra lub nadnerczy lub nowotworu prostaty.
Profil czterdziestolatka
Jeśli chcesz czuć się zdrowo i jednocześnie zachować dobry wygląd, musisz pamiętać o dostarczeniu wszystkich niezbędnych składników odżywczych. Wielu mężczyzn po 40 roku życia godzi się na swój “piwny brzuszek”. Pamiętaj, że nie jest on ani zdrowy, ani atrakcyjny, dlatego spróbuj się go pozbyć zanim będzie za późno.
Oto kilka prostych zasad:
- Unikaj przetworzonego jedzenia, chemicznych dodatków i konserwantów.
- Unikaj nadmiernego spożywania cukrów prostych.
- Ogranicz spożywanie soli, której nadmierna ilość powoduje podwyższenie ciśnienia.
- Zwróć uwagę na wielkość porcji, z wiekiem zapotrzebowanie kaloryczne spada i zmniejsza się tempo przemiany metabolizmu.
- Jednocześnie zaburzeniu ulega proces wchłaniania, więc zmniejszanie porcji może prowadzić do niedożywienia – skorzystaj z pomocy specjalisty.
- Pamiętaj o błonniku, zapewnia on prawidłową pracę jelit i chroni żołądek.
- Przyczyną zaburzeń związanych z trawieniem jest osłabiona flora bakteryjna. Zadbaj o odpowiednią ilość prebiotyków w diecie lub wspomóż się dodatkowymi suplementami.
- Pij dużo wody! Odpowiednie nawodnienie usprawnia pracę przewodu pokarmowego i pomaga zredukować obrzęk związany w nadmiernym gromadzeniem się wody.
Mężczyźni po 40 roku życia bardzo często skarżą się na obniżenie libido i problemy z erekcją. Często zamiast walczyć z problemem zwyczajnie poddają się, pogrążają się w depresji i obniżonym poczuciu własnej wartości. Myślisz o niebieskich tabletkach? Pamiętaj, że “leczą” one tylko chwilowo, przykry objaw bardziej złożonej dolegliwości.
Jednak nie poddawaj się – to efekt – cena życia w rozwiniętej cywilizacji. Odpowiednie postępowanie lecznicze przywróci sprawność seksualną i pozwoli na ponowny powrót erekcji.
- Naucz się zarządzać stresem! Nadmierny poziom stresu skutecznie zmniejsza ochotę na seks. Warto spróbować sprawdzonych technik relaksacyjnych, uprawiaj sport, który pomaga wyładować negatywne emocje lub skorzystaj ze specjalistycznej terapii redukcji stresu.
- Zadbaj o właściwy poziom witaminy D! Jest ona naturalnie syntezowana w organizmie podczas kontaktu ze światłem słonecznym. Jej odpowiednia ilość sprzyja produkcji testosteronu, który odpowiada za zachowania płciowe u mężczyzn, jednak utrzymanie jej właściwego poziomu w Twoim wieku wcale nie jest proste.
- Unikaj leków! Firmy farmaceutyczne wykorzystują niewiedzę i desperację wielu mężczyzn i wmawiają, że jedynie silne leki takie jak Viagra mogą skutecznie przywrócić erekcję. Nic bardziej mylnego! Ten lek uzależnia, więc coraz ciężej będzie osiągnąć wzwód w naturalny sposób. Coraz częściej mówi się także o wielu działaniach niepożądanych takich jak: obrzęk i podrażnienie prącia, zniszczenie ciał jamistych, zaburzenie widzenia, nudności, wymioty. Spróbuj naturalnych terapii jakie oferuje dzisiaj medycyna funkcjonalna.
- Regularnie uprawiaj sport, ale nie przesadzaj! Chcesz mieć więcej energii, poprawić krążenie, zredukować poziom stresu, a jednocześnie pozbyć się problemów związanych z erekcją? Zacznij ćwiczyć! Regularne treningi wzmacniają układ sercowo naczyniowy i prowadzą do podwyższenia poziomu testosteronu. Jakość erekcji jest uzależniona od odpowiedniego ukrwienia członka, dlatego jak znaczący wpływ ma prawidłowy przepływ krwi.
Aneta Strelau mgr dietetyki klinicznej, certyfikowany europejski specjalista leczenia otyłości (cert. SCOPE), Członkini Europejskiej Federacji Stowarzyszeń Dietetyków DIETS/ EFAD, Polskiego Stowarzyszenia Osób z Celiakią i Na Diecie Bezglutenowej, Polskiego Towarzystwa Dietetyki, Polskiego Towarzystwa Diabetologicznego, wiceprezes Fundacji promującej sport wśród dzieci i młodzieży „Warszawska Asocjacja Rugby. Właścicielka Poradni ,,Dietetyki Klinicznej Strelau”, Autorka ,,Poradnika dietetycznego dla Pacjenta z cukrzyca 2 cz. I” Poradnika dietetycznego dla Pacjentów z cukrzyca 2 cz. II” , ,, Dieta dla Dziecka”, ‘’Żywienie osób starszych w praktyce”.
Specjalista w zakresie leczenia otyłości oraz dietoterapii chorób autoimmunologicznych dzieci i dorosłych. Zajmuje się również poradnictwem dla dzieci objętymi opieką specjalistycznych poradni zaburzeń neurorozwojowych na terenie Warszawy. Wykładowca, uczestniczka licznych kongresów dotyczących żywienia klinicznego i chorób metabolicznych. Ekspert w licznych kampaniach edukacyjnych, w programach TV oraz w audycjach radiowych.
PRZECZYTAJ JESZCZE